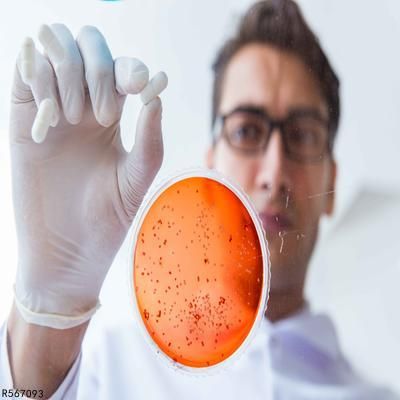

便秘拉黑色大便羊屎状 6种食物快速缓解便秘
2018-10-19 07:15网友分享
一、便秘吃什么食物缓解

地瓜
含丰富的抗氧化营养素-s胡萝卜素、维生素C及纤维质。洗净后连皮蒸熟或是烤过食用是最近普遍被推广的吃法,其可以促进肠胃的蠕动,帮助预防便秘,使肠道保持畅通。
竹笋
竹笋中所含的粗纤维在蔬菜中算是很高的,能刺激肠道蠕动、软化粪便并帮助其排除,减少粪便停留在肠道的时间。且因其长在地面下,较无农药残留的问题,是十分健康的食物。
黄瓜
性质寒凉,有清热下气之力,但多食易伤阳气。
冬瓜
性偏寒凉,有清热下行之力,多食可影响脾胃之阳,故脾胃虚寒者不宜多食。
丝瓜
性质偏凉,有滑肠致泻作用,但多食、久食可损及脾胃的。
黑木耳
又名木耳、云耳,性平,味甘,有补气生血之作用。其性滑利,还有润肠通便之功。对年老、气血不足便秘者,常食木耳大有裨益。
二、便秘的7大原因
原因1:没有定时排便
当你有便意时,千万不要先“忍一忍”。当你抑制了这一阵便意后,过后再想排便就很难了。因为久而久之肠道就会失去对粪便刺激的敏感性,大便在肠内停留过久就会变得又干又硬。所以,不妨将“排便”视为头等大事,当有便意时,要第一时间去解决它。
原因2:便便时看书或报纸
总有这样的一些人,去厕所的时候肯定要拿本书或报纸。这其实是个非常不好的习惯。大便不畅的时候,坐在马桶上,看着书、报纸,似乎很悠哉,不过,很多人可能不知道,10分钟以后,如果您还坐在马桶上,就会给肛门造成不必要的压迫,肛门的健康就是这样悄悄被破坏的。
原因3:常穿塑腰带或塑身衣
紧身衣抑制了调节排便活动的副交感神经,使大肠内分泌的消化液减少,在小肠中,将食物分解向前推的气力变弱,于是食物残渣在经过大肠的时候,要比正常的时候费时。这位教授指出,就是在这个过程中,很轻易产生便秘。所以说,便秘重症的女士,尽量不要穿紧身衣,特殊是睡觉的时候,更不要给身体太多的束缚。
原因4:习惯性地服用便秘药
如若长期服用便秘药,必定会对身体造成伤害。因为不能用自身能力进行排便,而是要借助外力,进而产生依赖影响。长期以往肠壁会变薄,从而伤害身体。
原因5:饮食过于精细少渣
随着我国经济发展和生活水平的提高,人们增加了动物性食物的消费,鸡、鸭、鱼、肉等荤食吃得越来越多,谷类食物吃得越来越少,且以精米、精面为主。由于食物过于精细,膳食纤维的摄入量减少,使得肠道蠕动缓慢、排便不畅而造成便秘。据我国居民营养调查发现,平均每人每日的膳食纤维摄入量已由过去的26克下降至17克。
原因6:液体量摄入不足
便秘患者一天最好喝8~10杯水。特别是早晨起来,空腹喝一杯温水,可以唤醒大肠,刺激胃肠的反应。再说,大便的70%都是水分,从这一点看,充足的水分摄取,在改善便秘方面是非常有必要的。因为如果我们的身体缺水,大便中的水分就会被大肠吸收出去,结果大便就会变得干燥。硬结的大便很难润滑地通过直肠和肛门,这就造成排便的痛苦,给肛门造成伤害,引起肛裂等不良症状。
原因7:运动量少
久坐少动,长期不喜欢运动,肠道蠕动慢,肌肉收缩无力,腹压降低使得排便动力不足,很容易发生便秘。
三、7款消除便秘的食谱

(1)芝麻粥
黑芝麻6克,粳米50克,蜂蜜少许。①烧热锅,放入芝麻,用中火炒熟,并有香味时,取出,粳米洗净。②粳米放入锅内,加清水适量,用武火烧沸后,转用文火煮,至米八成熟时,放芝麻,蜂蜜,拌匀,继续煮至米烂成粥。每日2次,作早、晚餐服用。具有润肠通便作用。
(2)红薯粥
红薯50克,小米50克。①红薯洗净去皮,切成一寸长,五分厚的小块。小米淘净。②小米、红薯放入锅内,加清水适量,用武火烧沸后,转用文火煮至米烂成粥。每日2次,早、晚餐服用。适用于习惯性便秘者食用。
(3)菠菜猪红汤
猪血250g,菠菜100g。猪血切成块状,新鲜菠菜洗净切成段,加水适量煮汤,调味服用,每日或隔日1次,连服2-3次。滋肾补肺,润肠通便。
(4)冰糖炖香蕉
香蕉1只,冰糖20g,香蕉去皮加冰糖,隔水炖服,每日1-2次,连服数日。滋阴养血,润燥滑肠。
(5)萝卜汤
将萝卜250克洗净,去皮切块,煮汤服。适用于习惯性便秘者。
(6)杏仁粥
取杏仁10克,煎汁去渣,与糯米50克,清水适畏共煨粥。每日2次。适用于大便不畅、咳喘日久者。
(7)荠菜瘦肉汤
荠菜150g,蜜枣6粒,瘦肉150g,油盐酌量。将原料洗净,蜜枣去核,瘦肉切成小块,放清水至煲内,同原料一起煮,待瘦肉煮烂后,调味即可饮用。消肿解毒,止血利水。
四、中医教你这样治疗便秘

1、大黄膏热敷方
材料:大黄适量,黄酒少许。
用法:将大黄打碎,研成粉末。将10克的大黄粉用黄酒调成软膏状。将此药膏敷于肚脐处,用纱布覆盖,并用热水袋在此药膏上热敷10分钟。可每日换药1次。
功效:此方具有泻热通便的功效。
2、硝皂敷方
材料:芒硝9克,皂角少许。
用法:把皂角研成细末;将芒硝用清水溶解成药膏状,调入皂角末。将此药膏敷在肚脐处,用纱布覆盖,用胶布固定。可每日换药1次。
功效:此方具有泻热通便、润燥软坚的功效。
3、桂萸巴豆敷
材料:巴豆、肉桂各1克,吴茱萸3克,生姜汁少许。
用法:将巴豆、肉桂和吴茱萸一起研成细末,用生姜汁调成糊状。将此药糊加热后敷于足三里穴和肚脐处。足三里穴位于外膝眼下10厘米(3寸),距胫骨前嵴1横指处。
功效:此方具有利水破积、温中通便的功效,多数患者在用药6-24个小时后即可通气排便。
提示:巴豆毒性强,不可内服,也不要让小孩接触。
阅读877 52 投诉相关知识
15种通便食物,帮你远离便秘、实现拉屎自由
便秘来看4个快速拉屎技巧,实现拉屎自由
史上最全拉屎大法!便秘党救星!通便神器
宝宝拉羊咩屎就是便秘吗?吃香蕉酸奶不如这3种对症汤药
老人便秘怎么快速排便 5大招治疗便秘
缓解便秘食物大法,拉拉更健康
大便羊屎蛋状是怎么回事
吃什么解决孕妇便秘 6种食物缓解孕妇便秘
便秘快速排便6个小方法
5天不拉屎大便哪去了 如何便秘通畅?
网址: 便秘拉黑色大便羊屎状 6种食物快速缓解便秘 https://www.trfsz.com/newsview1444779.html
推荐资讯
- 1发朋友圈对老公彻底失望的心情 12775
- 2BMI体重指数计算公式是什么 11235
- 3补肾吃什么 补肾最佳食物推荐 11199
- 4性生活姿势有哪些 盘点夫妻性 10428
- 5BMI正常值范围一般是多少? 10137
- 6在线基础代谢率(BMR)计算 9652
- 7一边做饭一边躁狂怎么办 9138
- 8从出汗看健康 出汗透露你的健 9063
- 9早上怎么喝水最健康? 8613
- 10五大原因危害女性健康 如何保 7828
